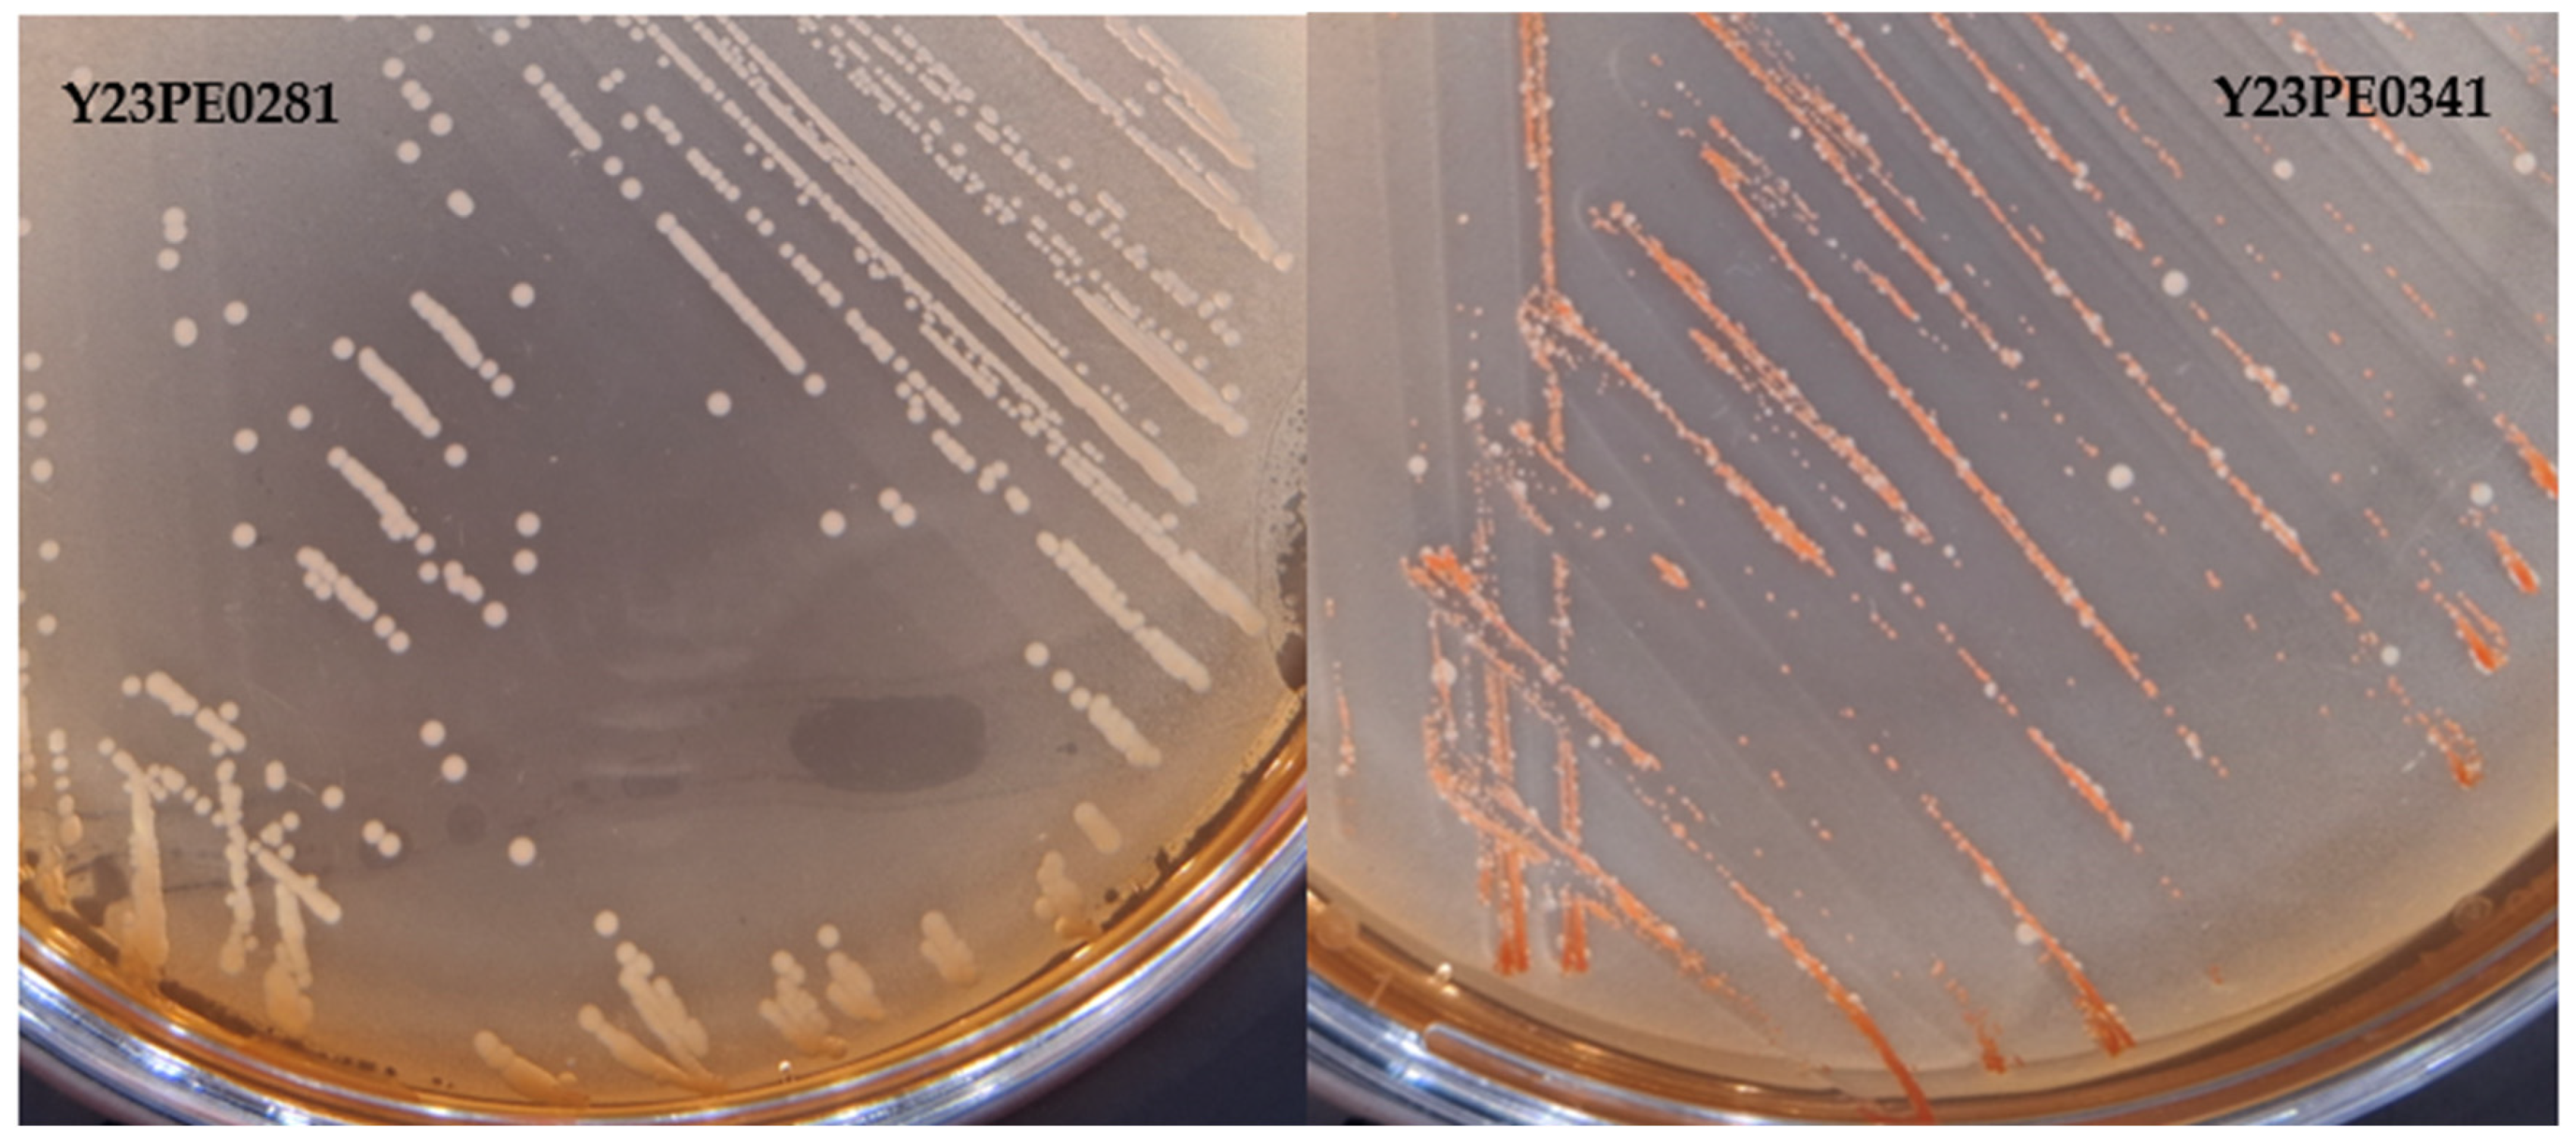
Applmicrobiol 05 00015 g002

Pathogenic Yersinia enterocolitica’s Contamination of Cheeks, Tongues, and Other Pork Meats at Retail in France, 2023
Abstract
1. Introduction
2. Materials and Methods
2.1. Sampling
2.2. Detection of Pathogenic Y. enterocolitica
2.3. Assays for Testing the Pathogenicity of the Strains
2.3.1. Biotyping
2.3.2. CR-MOX Test
2.3.3. DNA Extraction and Real-Time PCR for Detection of Virulence Genes
2.4. Sequencing and Genome Analysis
3. Results
3.1. Prevalence of Pathogenic Y. enterocolitica
3.2. Biotype and Plasmid pYV
3.3. Genetic Diversity of BT4 Strains (n = 57)
4. Discussion
5. Conclusions
Supplementary Materials
Author Contributions
Funding
Data Availability Statement
Acknowledgments
Conflicts of Interest
References
- EFSA; ECDC. The European Union one health 2023 zoonoses report. EFSA J. 2024, 22, e9106. [Google Scholar]
- Van Cauteren, D.; Le Strat, Y.; Sommen, C.; Bruyand, M.; Tourdjman, M.; Jourdan-Da Silva, N.; Couturier, E.; Fournet, N.; De Valk, H.; Desenclos, J.-C. Estimation de la morbidité et de la mortalité liées aux infections d’origine alimentaire en France métropolitaine, 2008-2013. Bull. Epidémiol. Hebd. 2018, 2–10. [Google Scholar]
- Tennant, S.M.; Grant, T.H.; Robins-Browne, R.M. Pathogenicity of Yersinia enterocolitica biotype 1A. FEMS Immunol. Med. Microbiol. 2003, 38, 127–137. [Google Scholar] [CrossRef] [PubMed]
- Mühlenkamp, M.; Oberhettinger, P.; Leo, J.C.; Linke, D.; Schütz, M.S. Yersinia adhesin A (YadA)--beauty & beast. Int. J. Med. Microbiol. 2015, 305, 252–258. [Google Scholar] [CrossRef] [PubMed]
- Le Guern, A.S.; Martin, L.; Savin, C.; Carniel, E. Yersiniosis in France: Overview and potential sources of infection. Int. J. Infect. Dis. 2016, 46, 1–7. [Google Scholar] [CrossRef] [PubMed]
- Fondrevez, M.; Minvielle, B.; Labbé, A.; Houdayer, C.; Rose, N.; Esnault, E.; Denis, M. Prevalence of pathogenic Yersinia enterocolitica in slaughter-aged pigs during a one-year survey, 2010-2011, France. Int. J. Food Microbiol. 2014, 174, 56–62. [Google Scholar] [CrossRef]
- Nesbakken, T.; Eckner, K.; Høidal, H.K.; Røtterud, O.J. Occurrence of Yersinia enterocolitica and Campylobacter spp. in slaughter pigs and consequences for meat inspection, slaughtering, and dressing procedures. Int. J. Food Microbiol. 2003, 80, 231–240. [Google Scholar] [CrossRef] [PubMed]
- Liang, J.; Wang, X.; Xiao, Y.; Cui, Z.; Xia, S.; Hao, Q.; Yang, J.; Luo, L.; Wang, S.; Li, K.; et al. Prevalence of Yersinia enterocolitica in pigs slaughtered in Chinese abattoirs. Appl. Environ. Microbiol. 2012, 78, 2949–2956. [Google Scholar] [CrossRef] [PubMed]
- Esnault, E.; Rouaud, A.; Labbé, A.; Houdayer, C.; Bailly, Y.; Houard, E.; Bougeard, S.; Paboeuf, F.; Eterradossi, N.; Chemaly, M.; et al. Controlled Experimental Infection in Pigs with a Strain of Yersinia enterocolitica Harboring Genetic Markers for Human Pathogenicity: Colonization and Stability. Infect. Immun. 2023, 91, e0015723. [Google Scholar] [CrossRef] [PubMed]
- ISO 10273:2017; Microbiology of food chain—Horizontal method for the detection of pathogenic Yersinia enterocolitica. ISO: Geneva, Switzerland, 2017.
- Weagant, S.D. A new chromogenic agar medium for detection of potentially virulent Yersinia enterocolitica. J. Microbiol. Methods 2008, 72, 185–190. [Google Scholar] [CrossRef]
- Kot, B.; Piechota, M.; Jakubczak, A. Analysis of occurrence of virulence genes among Yersinia enterocolitica isolates belonging to different biotypes and serotypes. Pol. J. Vet. Sci. 2010, 13, 13–19. [Google Scholar] [PubMed]
- Fondrevez, M.; Labbé, A.; Houdayer, C.; Denis, M. Genetic characterization of Yersinia enterocolitica collected from tonsils of slaughtered pigs. In Proceedings of the Fifth International Symposium on the Epidemiology and Control of Foodborn Pathogens in Pork, Maastricht, The Netherlands, 19–22 June 2011. [Google Scholar]
- Chen, S.; Zhou, Y.; Chen, Y.; Gu, J. fastp: An ultra-fast all-in-one FASTQ preprocessor. Bioinformatics 2018, 34, i884–i890. [Google Scholar] [CrossRef]
- Ondov, B.D.; Treangen, T.J.; Melsted, P.; Mallonee, A.B.; Bergman, N.H.; Koren, S.; Phillippy, A.M. Mash: Fast genome and metagenome distance estimation using MinHash. Genome Biol. 2016, 17, 132. [Google Scholar] [CrossRef] [PubMed]
- Schwengers, O.; Jelonek, L.; Dieckmann, M.A.; Beyvers, S.; Blom, J.; Goesmann, A. Bakta: Rapid and standardized annotation of bacterial genomes via alignment-free sequence identification. Microb. Genom. 2021, 7, 000685. [Google Scholar] [CrossRef] [PubMed]
- Royer, G.; Decousser, J.W.; Branger, C.; Dubois, M.; Médigue, C.; Denamur, E.; Vallenet, D. PlaScope: A targeted approach to assess the plasmidome from genome assemblies at the species level. Microb. Genom. 2018, 4, e000211. [Google Scholar] [CrossRef] [PubMed]
- Galata, V.; Fehlmann, T.; Backes, C.; Keller, A. PLSDB: A resource of complete bacterial plasmids. Nucleic Acids Res. 2019, 47, D195–D202. [Google Scholar] [CrossRef] [PubMed]
- Zhou, Z.; Alikhan, N.F.; Mohamed, K.; The Agama Study Group; Achtman, M. The EnteroBase user’s guide, with case studies on Salmonella transmissions, Yersinia pestis phylogeny and Escherichia core genomic diversity. Genome Res. 2020, 30, 138–152. [Google Scholar] [CrossRef]
- Hall, M.; Chattaway, M.A.; Reuter, S.; Savin, C.; Strauch, E.; Carniel, E.; Connor, T.; Van Damme, I.; Rajakaruna, L.; Rajendram, D.; et al. Use of whole-genus genome sequence data to develop a multilocus sequence typing tool that accurately identifies Yersinia isolates to the species and subspecies levels. J. Clin. Microbiol. 2015, 53, 35–42. [Google Scholar] [CrossRef] [PubMed]
- Zhou, Z.; Alikhan, N.F.; Sergeant, M.J.; Luhmann, N.; Vaz, C.; Francisco, A.P.; Carrico, J.A.; Achtman, M. GrapeTree: Visualization of core genomic relationships among 100,000 bacterial pathogens. Genome Res. 2018, 28, 1395–1404. [Google Scholar] [CrossRef]
- Le Guern, A.-S.; Savin, C.; Chereau, F.; Tessier, S.; Guglielmini, J.; Brémont, S.; Pizarro-Cerdá, J. A novel cgMLST for genomic surveillance of Yersinia enterocolitica infections in France allowed the detection and investigation of outbreaks in 2017−2021. Microbiol. Spectr. 2024, 12, e0050424. [Google Scholar] [CrossRef] [PubMed]
- Silva, M.; Machado, M.P.; Silva, D.N.; Rossi, M.; Moran-Gilad, J.; Santos, S.; Ramirez, M.; Carriço, J.A. chewBBACA: A complete suite for gene-by-gene schema creation and strain identification. Microb. Genom. 2018, 4, 000166. [Google Scholar] [CrossRef]
- Mamede, R.; Vila-Cerqueira, P.; Silva, M.; Carriço, J.A.; Ramirez, M. Chewie Nomenclature Server (chewie-NS): A deployable nomenclature server for easy sharing of core and whole genome MLST schemas. Nucleic Acids Res. 2021, 49, D660–D666. [Google Scholar] [CrossRef] [PubMed]
- Nguyen, L.T.; Schmidt, H.A.; von Haeseler, A.; Minh, B.Q. IQ-TREE: A fast and effective stochastic algorithm for estimating maximum-likelihood phylogenies. Mol. Biol. Evol. 2015, 32, 268–274. [Google Scholar] [CrossRef]
- Letunic, I.; Bork, P. Interactive Tree Of Life (iTOL) v5: An online tool for phylogenetic tree display and annotation. Nucleic Acids Res. 2021, 49, W293–W296. [Google Scholar] [CrossRef] [PubMed]
- Roguet, C. Pig and pork production in France: Characteristics, changes and challenges. In Proceedings of the EPP (European Pig Production) Congress, Nantes, France, 29 May 2024. [Google Scholar]
- Zdolec, N.; Kiš, M.; Jankuloski, D.; Blagoevska, K.; Kazazić, S.; Pavlak, M.; Blagojević, B.; Antić, D.; Fredriksson-Ahomaa, M.; Pažin, V. Prevalence and Persistence of Multidrug-Resistant Yersinia enterocolitica 4/O:3 in Tonsils of Slaughter Pigs from Different Housing Systems in Croatia. Foods 2022, 11, 1459. [Google Scholar] [CrossRef]
- Fondrevez, M.; Labbé, A.; Houard, E.; Fravalo, P.; Madec, F.; Denis, M. A simplified method for detecting pathogenic Yersinia enterocolitica in slaughtered pig tonsils. J. Microbiol. Methods 2010, 83, 244–249. [Google Scholar] [CrossRef] [PubMed]
- Murase, K.; Watanabe, T.; Arai, S.; Kim, H.; Tohya, M.; Ishida-Kuroki, K.; Võ, T.H.; Nguyễn, T.P.B.; Nakagawa, I.; Osawa, R.; et al. Characterization of pig saliva as the major natural habitat of Streptococcus suis by analyzing oral, fecal, vaginal, and environmental microbiota. PLoS ONE 2019, 14, e0215983. [Google Scholar] [CrossRef] [PubMed]
- Peruzy, M.F.; Aponte, M.; Proroga, Y.T.R.; Capuano, F.; Cristiano, D.; Delibato, E.; Houf, K.; Murru, N. Yersinia enterocolitica detection in pork products: Evaluation of isolation protocols. Food Microbiol. 2020, 92, 103593. [Google Scholar] [CrossRef] [PubMed]
- Doyle, M.P.; Hugdahl, M.B.; Taylor, S.L. Isolation of virulent Yersinia enterocolitica from porcine tongues. Appl. Environ. Microbiol. 1981, 42, 661–666. [Google Scholar] [CrossRef] [PubMed]
- Fredriksson-Ahomaa, M.; Hielm, S.; Korkeala, H. High prevalence of yadA-positive Yersinia enterocolitica in pig tongues and minced meat at the retail level in Finland. J. Food Prot. 1999, 62, 123–127. [Google Scholar] [CrossRef]
- Lorencova, A.; Slany, M. Prevalence of pathogenic Yersinia enterocolitica in minced meat, pig tongues and hearts at the retail level in the Czech Republic detected by real time PCR. Potravinarstvo Slovak. J. of Food Sci. 2016, 10, 282–286. [Google Scholar] [CrossRef] [PubMed]
- Swanenburg, M.; Urlings, H.A.; Snijders, J.M.; Keuzenkamp, D.A.; van Knapen, F. Salmonella in slaughter pigs: Prevalence, serotypes and critical control points during slaughter in two slaughterhouses. Int. J. Food Microbiol. 2001, 70, 243–254. [Google Scholar] [CrossRef]
- Autio, T.; Säteri, T.; Fredriksson-Ahomaa, M.; Rahkio, M.; Lundén, J.; Korkeala, H. Listeria monocytogenes contamination pattern in pig slaughterhouses. J. Food Prot. 2000, 63, 1438–1442. [Google Scholar] [CrossRef]
- Feurer, C.; Piaudel, G.; Le Roux, A.; Minvielle, B. Yersinia enterocolitica contamination of pig tonsils, carcasses and feces in one French slaughterhouse. In Proceedings of the 14èmes Journées Sciences du Muscle et Technologies des Viandes, Caen, France, 13–14 November 2012; pp. 65–66. [Google Scholar]
- Terentjeva, M.; Ķibilds, J.; Gradovska, S.; Alksne, L.; Streikiša, M.; Meistere, I.; Valciņa, O. Prevalence, virulence determinants, and genetic diversity in Yersinia enterocolitica isolated from slaughtered pigs and pig carcasses. Int. J. Food Microbiol. 2022, 376, 109756. [Google Scholar] [CrossRef] [PubMed]
- Denis, M.; Houard, E.; Ouedraogo, A.; Le Berre, L.; Feurer, C.; Pizarro-cerda, J.; Savin, C.; Le Guern, A.-S. Cold survival and pathogenicity of Yersinia enterocolitica BT4 strains isolated from pigs and genetically close or not to strains isolated from human cases. Anim.—Sci. Proc. 2024, 15, 265. [Google Scholar] [CrossRef]
- Paerregaard, A.; Espersen, F.; Skurnik, M. Role of the Yersinia outer membrane protein YadA in adhesion to rabbit intestinal tissue and rabbit intestinal brush border membrane vesicles. APMIS 1991, 99, 226–232. [Google Scholar] [CrossRef] [PubMed]
- Farmer, J.J., 3rd; Carter, G.P.; Miller, V.L.; Falkow, S.; Wachsmuth, I.K. Pyrazinamidase, CR-MOX agar, salicin fermentation-esculin hydrolysis, and D-xylose fermentation for identifying pathogenic serotypes of Yersinia enterocolitica. J. Clin. Microbiol. 1992, 30, 2589–2594. [Google Scholar] [CrossRef] [PubMed]
- Thoerner, P.; Bin Kingombe, C.I.; Bögli-Stuber, K.; Bissig-Choisat, B.; Wassenaar, T.M.; Frey, J.; Jemmi, T. PCR detection of virulence genes in Yersinia enterocolitica and Yersinia pseudotuberculosis and investigation of virulence gene distribution. Appl. Environ. Microbiol. 2003, 69, 1810–1816. [Google Scholar] [CrossRef]
- Raymond, P.; Houard, E.; Denis, M.; Esnault, E. Diversity of Yersinia enterocolitica isolated from pigs in a French slaughterhouse over 2 years. MicrobiologyOpen 2019, 8, e00751. [Google Scholar] [CrossRef] [PubMed]

| Genes | Primer Sequence | First Step | Cycle of Amplification | Melt Curve | Size in bp | Expected Tm |
|---|---|---|---|---|---|---|
| ail | F—TGG TTA TGC GCA AAG CCA TGT | 94 °C, 2 min | 35 cycles of following: | 55 °C -> 89 °C | ||
| R—TGG AAG TGG GTT GAA TTG CA | Denaturation, 94 °C, 30 s; Annealing, 57 °C, 30 s; Extension, 72 °C, 60 s. | increment of 0.5 °C every 5 s | 356 | 82.5 °C | ||
| yadA | F—CAG ATA CAC CTG CCT TCC ATC T | 94 °C, 2 min | 35 cycles of following: | 55 °C -> 95 °C | ||
| R—CTC GAC ATA TTC CTC AAC ACG C | Denaturation, 94 °C, 60 s; Annealing, 58 °C, 60 s; Extension, 72 °C, 60 s. | increment of 0.5 °C every 5 s | 747 | 86 °C |
| Negative | Positive | Total | % of Positive | IC95% | p-Value | ||
|---|---|---|---|---|---|---|---|
| Matrix | Cheek | 93 | 18 | 111 | 16.2 | 10.4–21.9 | |
| Tongue | 63 | 41 | 104 | 39.4 | 31.5–47.3 | p = 4.6 × 10−16 | |
| Meat | 159 | 1 | 160 | 0.6 | 0.02–3.4 | ||
| Total | 315 | 60 | 375 | 16.0 | 12.8–19.1 | ||
| Packaging | Modified atmosphere | 117 | 28 | 145 | 19.3 | 13.9–24.7 | |
| Under film | 154 | 26 | 180 | 14.4 | 10.1–18.7 | p = 0.395 | |
| Under vacuum | 41 | 6 | 47 | 12.7 | 4.8–20.7 | ||
| nd ** | 3 | 0 | 3 | 0 | - | ||
| Total | 315 | 60 | 375 | 16.0 | 12.8–19.1 | ||
| Season | Spring | 81 | 18 | 99 | 18.2 | 11.8–24.5 | |
| Summer | 62 | 12 | 74 | 16.2 | 9.2–23.2 | p = 0.759 | |
| Autumn | 172 | 30 | 202 | 14.9 | 10.7–18.9 | ||
| Total | 315 | 60 | 375 | 16.0 | 12.8–19.1 |
Disclaimer/Publisher’s Note: The statements, opinions and data contained in all publications are solely those of the individual author(s) and contributor(s) and not of MDPI and/or the editor(s). MDPI and/or the editor(s) disclaim responsibility for any injury to people or property resulting from any ideas, methods, instructions or products referred to in the content. |
© 2025 by the authors. Licensee MDPI, Basel, Switzerland. This article is an open access article distributed under the terms and conditions of the Creative Commons Attribution (CC BY) license (https://creativecommons.org/licenses/by/4.0/).
Share and Cite
Denis, M.; Felten, A.; Ducret, L.; Houard, E.; Tasset, M.; Novi, D.; Chemaly, M. Pathogenic Yersinia enterocolitica’s Contamination of Cheeks, Tongues, and Other Pork Meats at Retail in France, 2023. Appl. Microbiol. 2025, 5, 15. https://doi.org/10.3390/applmicrobiol5010015
Denis M, Felten A, Ducret L, Houard E, Tasset M, Novi D, Chemaly M. Pathogenic Yersinia enterocolitica’s Contamination of Cheeks, Tongues, and Other Pork Meats at Retail in France, 2023. Applied Microbiology. 2025; 5(1):15. https://doi.org/10.3390/applmicrobiol5010015
Chicago/Turabian StyleDenis, Martine, Arnaud Felten, Linda Ducret, Emmanuelle Houard, Manon Tasset, Delphine Novi, and Marianne Chemaly. 2025. "Pathogenic Yersinia enterocolitica’s Contamination of Cheeks, Tongues, and Other Pork Meats at Retail in France, 2023" Applied Microbiology 5, no. 1: 15. https://doi.org/10.3390/applmicrobiol5010015
APA StyleDenis, M., Felten, A., Ducret, L., Houard, E., Tasset, M., Novi, D., & Chemaly, M. (2025). Pathogenic Yersinia enterocolitica’s Contamination of Cheeks, Tongues, and Other Pork Meats at Retail in France, 2023. Applied Microbiology, 5(1), 15. https://doi.org/10.3390/applmicrobiol5010015

